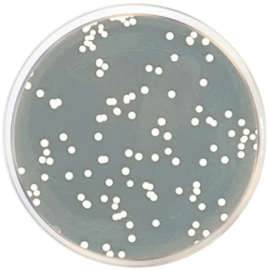
main product photo

Close
SABOURAUD DEXTROSE AGAR (Eur. Pharma.) 500 grams/bottle
SKU
CDL/1024
Brand
CONDALAB
Pre-order (Deliver in 8 to 12 weeks)
Sabouraud Dextrose Agar can be used for cultivating yeasts, molds (as cultivating pathogenic fungi, particularly those associated with skin infections) and aciduric microorganisms. This medium is also used for determining the microbial and fungal content of cosmetics and for the mycological evaluation of food.
The formula is based on the European Pharmacopoeia. Dextrose is the fermentable carbohydrate providing carbon and energy. Peptone mixture provides nitrogen, vitamins, minerals and amino acids essential for growth. Bacteriological agar is the solidifying agent. The high dextrose concentration and acidic pH make this medium selective for fungi.
Georg et al. demonstrated that the basic agar fortified by three antibiotics considerably improves the isolation of pathogenic fungi from heavily contaminated sources. To prepare a selective culture medium aseptically add the following for every liter of the medium before use: 0,4 g Cycloheximide; 20 units Penicillin; 40 mg Streptomycin.
One can obtain a very rich Sabouraud medium by dissolving the medium in one liter of Heart Infusion (Cat. 1714).
The European Pharmacopoeia recommends this medium in the paragraph 2.6.12: Microbiological examination of non sterile products: Microbial enumeration test for the examination of TYMC in products. In the paragraph 2.6.13: "Microbiological examination of non-sterile products: Test for specified microorganisms" for the test of Candida albicans in products.
Sabouraud Dextrose Agar can be used for cultivating yeasts, molds (as cultivating pathogenic fungi, particularly those associated with skin infections) and aciduric microorganisms. This medium is also used for determining the microbial and fungal content of cosmetics and for the mycological evaluation of food.
The formula is based on the European Pharmacopoeia. Dextrose is the fermentable carbohydrate providing carbon and energy. Peptone mixture provides nitrogen, vitamins, minerals and amino acids essential for growth. Bacteriological agar is the solidifying agent. The high dextrose concentration and acidic pH make this medium selective for fungi.
Georg et al. demonstrated that the basic agar fortified by three antibiotics considerably improves the isolation of pathogenic fungi from heavily contaminated sources. To prepare a selective culture medium aseptically add the following for every liter of the medium before use: 0,4 g Cycloheximide; 20 units Penicillin; 40 mg Streptomycin.
One can obtain a very rich Sabouraud medium by dissolving the medium in one liter of Heart Infusion (Cat. 1714).
The European Pharmacopoeia recommends this medium in the paragraph 2.6.12: Microbiological examination of non sterile products: Microbial enumeration test for the examination of TYMC in products. In the paragraph 2.6.13: "Microbiological examination of non-sterile products: Test for specified microorganisms" for the test of Candida albicans in products.
| Brand | CONDALAB |
|---|
Write Your Own Review

Validate your login